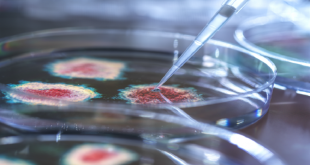

منبر العراق الحر : وجد باحثون أن فئة من الأدوية القديمة المضادة للذهان يمكن أن تكون خيارا علاجيا جديدا واعدا للمصابين بداء السكري من النوع الثاني. وقد يساعد هذا في سد حاجة المرضى غير القادرين على تناول العلاجات الأخرى المتاحة حاليا. ويوضح جون أوشر، الأستاذ في كلية الصيدلة والعلوم الصيدلانية …
أقرأ المزيداكتشاف السبب الأكثر شيوعا لارتفاع ضغط الدم وعلاجه
منبر العراق الحر : توصلت دراسة جديدة إلى أن فحصا مدته 10 دقائق قد يسمح باكتشاف السبب الأكثر شيوعا لارتفاع ضغط الدم وعلاجه. واستخدم الأطباء في جامعة كوين ماري بلندن ومستشفى سانت بارثولوميو بلندن ومستشفى جامعة كامبريدج نوعا جديدا من الأشعة المقطعية لإضاءة العقيدات الدقيقة في الغدة الهرمونية وعلاج ارتفاع …
أقرأ المزيدعلاج جديد وواعد لمتلازمة قاتلة “مستعصية”!
منبر العراق الحر : تعرف متلازمة ألاجيل بأنها اضطراب وراثي قاتل يؤثر على أعضاء وأنظمة مختلفة أبرزها الكبد. وفي الوقت الحالي، لا يوجد علاج معروف له – لكن العلماء حددوا الآن علاجا محتملا أن يكون فعالا. ويستهدف العقار الذي تم تطويره حديثا، والذي يسمى NoRA1، مسار Notch، وهو نظام إشارات …
أقرأ المزيدالشرق التقى بالغرب ومكة في الوسط.. أسرار الكرة الأرضية المقلوبة!
منبر العراق الحر : خلال ذروة الصراع بين الشرق الإسلامي والغرب المسيحي جنوب وغرب المتوسط في القرن 12 ميلادي، استعان النورمانديون في صقلية بعالم عربي فذ لرسم خريطة للعالم. الشرق التقى بالغرب ومكة في الوسط.. أسرار الكرة الأرضية المقلوبة!”نساء المتعة” في مواجهة “ميتسوبيشي” و”تويوتا” و”نيسان”! على الرغم من مقولة الشاعر …
أقرأ المزيداختبار جديد يمكن أن يساعد في العثور على فيروسات مخفية لم نشهدها من قبل!
منبر العراق الحر : أظهرت جائحة فيروس كورونا أنه لا ينبغي القلق من الفيروسات المعروفة فقط: يحتاج العلماء والأطباء إلى البحث عن متحورات جديدة وناشئة يمكنها أن تتهرب من العلاجات الحالية وتفاجئنا. وهناك عدد من الطرق التي يمكننا من خلالها اكتشاف الفيروسات الجديدة التي قد تشكل تهديدا لصحة الإنسان. فمراقبة …
أقرأ المزيدعصير مدعم يمكن أن يوفر انخفاضات “كبيرة” في الدهون الحشوية
منبر العراق الحر : أظهرت بعض المشروبات نتائج واعدة في إدارة الوزن عند دمجها في نمط حياة صحي. وبعد استكماله بالكالسيوم وفيتامين (د)، قد يؤدي عصير البرتقال على وجه التحديد إلى انخفاض كبير في الدهون داخل البطن. وأشارت العديد من الدراسات إلى أن الكالسيوم وفيتامين (د) قد يلعبان دورا في …
أقرأ المزيدنجاح اختبار البنكرياس الاصطناعي على 26 متطوعا مصابا بداء السكري
منبر العراق الحر : نجح الأطباء البريطانيون في اختبار بنكرياس اصطناعي لتثبيت مستوى السكر والأنسولين في جسم 26 متطوعا مصابا بالنوع الثاني من داء السكري. وتشير مجلة Nature Medecine، إلى أن تطور داء السكري بنوعيه الأول والثاني، يؤدي إلى اضطراب عملية التمثيل الغذائي للسكر ويسبب خللا في جسم الشخص المصاب. …
أقرأ المزيدتقنية تكشف عن عالم خفي في علم الأحياء لم نشهده من قبل!
منبر العراق الحر : تتكون الحياة كلها من خلايا أصغر بعدة مقادير من حبة ملح. وتخفي هياكلها التي تبدو بسيطة المظهر النشاط الجزيئي المعقد الذي يمكّنها من تنفيذ الوظائف التي تحافظ على الحياة. وقد بدأ الباحثون في تصور هذا النشاط إلى مستوى من التفاصيل لم يكونوا قادرين عليه من قبل. …
أقرأ المزيدهل تبدو أكبر سنّا بالنسبة لعمرك؟ .. قد تكون أكثر عرضة لهذه الأمراض!
منبر العراق الحر : حذر باحثون من أنه إذا كنت تبدو أكبر من عمرك الحقيقي، فقد يكون ذلك علامة على أنك أكثر عرضة لخطر الإصابة بأمراض مرتبطة بالعمر مثل هشاشة العظام وفقدان السمع والساد (إعتام عدسة العين). وخمّن الأكاديميون في هولندا عمر حوالي 2700 شخص تتراوح أعمارهم بين 50 و90 …
أقرأ المزيدعلماء بطرسبورغ يبتكرون عقارا يحفظ الذاكرة
منبر العراق الحر : أعلن المكتب الإعلامي لجامعة بطرسبورغ للعلوم التطبقية، أن علماء الجامعة ابتكروا عقارا يحفظ الذاكرة، وفعال في مكافحة مرض الزهايمر. ويشير المكتب إلى أن الاختبارات التي أجريت على الحيوانات المخبرية أثبتت فعالية العقار. وتقول يلينا بوبوغايفا، كبيرة الباحثين في مختبر التنكس العصبي الجزيئي التابع لمعهد النظم الطبية …
أقرأ المزيد منبر العراق الحر منبر العراق الحر
منبر العراق الحر منبر العراق الحر